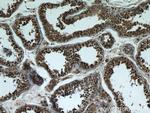
BBS7 Antibody in Immunohistochemistry (Paraffin) (IHC (P))

Search
Proteintech
BBS7 Polyclonal Antibody
{{$productOrderCtrl.translations['antibody.pdp.commerceCard.promotion.promotions']}}
{{$productOrderCtrl.translations['antibody.pdp.commerceCard.promotion.viewpromo']}}
{{$productOrderCtrl.translations['antibody.pdp.commerceCard.promotion.promocode']}}: {{promo.promoCode}} {{promo.promoTitle}} {{promo.promoDescription}}. {{$productOrderCtrl.translations['antibody.pdp.commerceCard.promotion.learnmore']}}
产品信息
18961-1-AP
种属反应
已发表种属
宿主/亚型
分类
类型
抗原
偶联物
形式
浓度
规格
纯化类型
保存液
内含物
保存条件
运输条件
产品详细信息
Immunogen sequence: MDLILNRMD YLQVGVTSQK TMKLIPASRH RATQKVVIGD HDGVVMCFGM KKGEAAAVFK TLPGPKIARL ELGGVINTPQ EKIFIAAASE IRGFTKRGKQ FLSFETNLTE SIKAMHISGS DLFLSASYIY NHYCDCKDQH YYLSGDKIND VICLPVERLS RITPVLACQD RVLRVLQGSD VMYAVEVPGP PTVLALHNGN GGDSGEDLLF GTSDGKLALI QITTSKPVRK WEIQNEKKRG GILCIDSFDI VGDGVKDLLV GRDDGMVEVY SFDNANEPVL RFDQMLSESV TSIQGGCVGK DSYDEIVVST YSGWVTGLTT EPIHKESGPG EELKINQEMQ NKISSLRNEL E (1-350 aa encoded by BC032691)
靶标信息
BBS7, also named as BBS2L1, is a component of the BBSome complex which is required for ciliogenesis but is dispensable for centriolar satellite function. BBS7 is mediated in part by the Rab8 GDP/GTP exchange factor, which localizes to the basal body and contacts the BBSome.
仅用于科研。不用于诊断过程。未经明确授权不得转售。
生物信息学
蛋白别名: Bardet-Biedl syndrome 7 protein; Bardet-Biedl syndrome 7 protein homolog; BBS2-like 1; BBS2-like protein 1; BBSome complex member BBS7; FLJ10715; unnamed protein product
基因别名: 8430406N16Rik; BBS2L1; BBS7
UniProt ID: (Human) Q8IWZ6, (Mouse) Q8K2G4
Entrez Gene ID: (Human) 55212, (Mouse) 71492